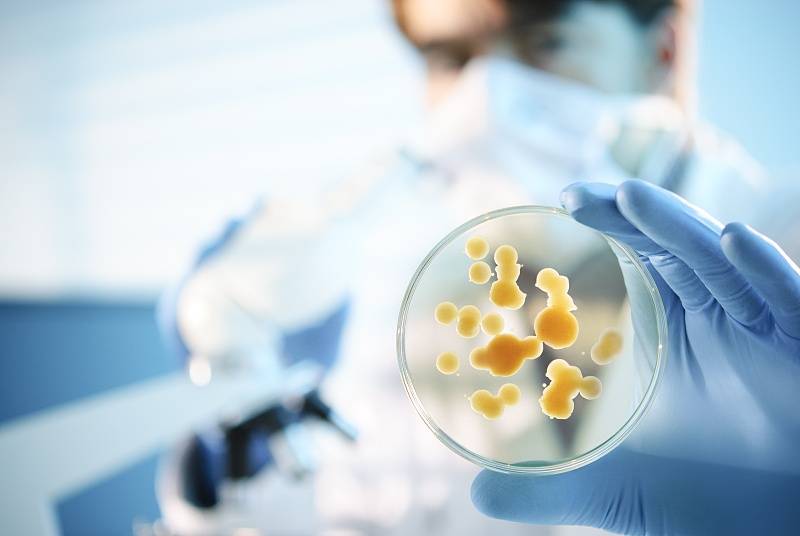
酵母菌的发酵饲料,真棒!
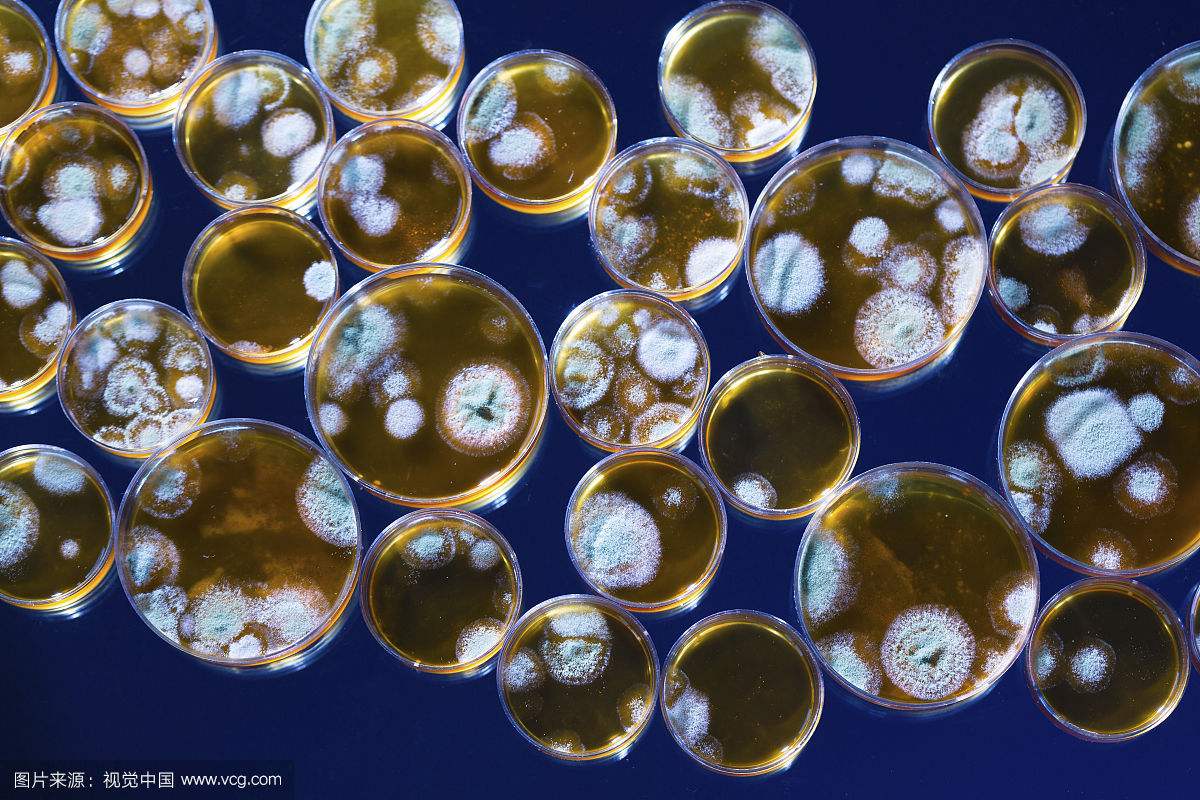
发酵传播者说目前的趋势可能会阻止我们的"疯狂的细菌恐惧症"

细菌发酵

揭开发酵桶里乳酸菌克制其它细菌的面纱
图片尺寸1200x801
聊聊神乎其神的"酵母(细菌)发酵液"吧
图片尺寸720x547
酵母菌的发酵饲料,真棒!
图片尺寸800x536
中考生物技术考点:细菌,真菌与食品制作的发酵原理
图片尺寸652x522
发酵菌种-1ppt
图片尺寸1080x810
发酵离不开真 菌和细菌体内酶
图片尺寸1080x810
你的手机有多脏:病菌数超男厕冲水开关18倍
图片尺寸500x280
细菌型腐乳生产工艺流程
图片尺寸792x430
程扬健:带细菌回家发酵
图片尺寸400x250
金坛人自制发酵食物有风险日常饮食需防范
图片尺寸1080x608
发酵传播者说目前的趋势可能会阻止我们的"疯狂的细菌恐惧症"
图片尺寸1200x800
细菌,真菌与食品的制作 发酵现象: 一杯温水 糖 酵母 搅 拌
图片尺寸1080x810
生物大师细菌和真菌的繁殖发酵的奥秘
图片尺寸1080x569
瓦克生物技术采用生物技术工艺在不锈钢发酵罐中诱导细菌(在本例中是
图片尺寸2430x1620
自制发酵饮料康普茶"细菌与酵母共生培养"
图片尺寸1200x801
细菌发酵生成纯天然面料 号称最环保衣服
图片尺寸466x261
酵素中的细菌竟然这么多!|酵素|发酵|微生物
图片尺寸640x480
生物大师细菌和真菌的繁殖发酵的奥秘
图片尺寸1080x540
抗植物病原真菌海洋细菌l_1-9菌株的发酵条件优化
图片尺寸438x383
黄豆饼粉 高温低温脱脂工业发酵氮源 实验试剂生物细菌培养基原料
图片尺寸800x800